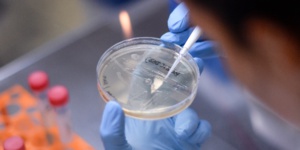
Coronavirus: premiers essais cliniques d’un vaccin en Allemagne Coronavirus: premiers essais cliniques d’un vaccin en Allemagne

De premiers essais cliniques d’un vaccin contre le nouveau coronavirus vont être lancés en Allemagne par la société BioNTech, basée à Mayence, en lien avec le laboratoire américain Pfizer, a annoncé mercredi l’autorité fédérale compétente.
Il s’agit « seulement du quatrième essai sur l’homme » dans le monde d’un vaccin contre le Covid-19, précise l’autorité régulatrice.
Ces essais cliniques seront dans un premier temps menés sur 200 volontaires sains âgés de 18 à 55 ans, précise l’Institut Paul Ehrlich (IPE) sur son site internet. D’autres phases de tests seront menées sur d’autres volontaires dans les prochains mois
« L’expérimentation sur l’homme est une étape importante sur la voie de la mise au point de vaccins sûrs et efficaces contre le Covid-19 pour la population en Allemagne et au-delà », a estime l’IPE.
Des essais cliniques devraient être menés également par Pfizer aux Etats-Unis, lorsque le feu vert aura été donné par les autorités sanitaires, indique de son côté BioNTech, spécialisé jusqu’ici dans la recherche de traitements contre le cancer.
Ces premiers essais en Allemagne doivent consister, selon l’IPE, à « déterminer la tolérance générale du vaccin testé et sa capacité à proposer une réponse immunitaire contre l’agent pathogène », un virus à ARN, qui a la particularité de muter.
D’autres essais cliniques devraient être menés dans les prochains moins en Allemagne par des laboratoires, estime l’IPE.
Environ 150 projets de vaccins sont actuellement en cours dans le monde face au nouveau coronavirus.
Il s’agit « seulement du quatrième essai sur l’homme » dans le monde d’un vaccin contre le Covid-19, précise l’autorité régulatrice.
Ces essais cliniques seront dans un premier temps menés sur 200 volontaires sains âgés de 18 à 55 ans, précise l’Institut Paul Ehrlich (IPE) sur son site internet. D’autres phases de tests seront menées sur d’autres volontaires dans les prochains mois
« L’expérimentation sur l’homme est une étape importante sur la voie de la mise au point de vaccins sûrs et efficaces contre le Covid-19 pour la population en Allemagne et au-delà », a estime l’IPE.
Des essais cliniques devraient être menés également par Pfizer aux Etats-Unis, lorsque le feu vert aura été donné par les autorités sanitaires, indique de son côté BioNTech, spécialisé jusqu’ici dans la recherche de traitements contre le cancer.
Ces premiers essais en Allemagne doivent consister, selon l’IPE, à « déterminer la tolérance générale du vaccin testé et sa capacité à proposer une réponse immunitaire contre l’agent pathogène », un virus à ARN, qui a la particularité de muter.
D’autres essais cliniques devraient être menés dans les prochains moins en Allemagne par des laboratoires, estime l’IPE.
Environ 150 projets de vaccins sont actuellement en cours dans le monde face au nouveau coronavirus.

FRANCE


